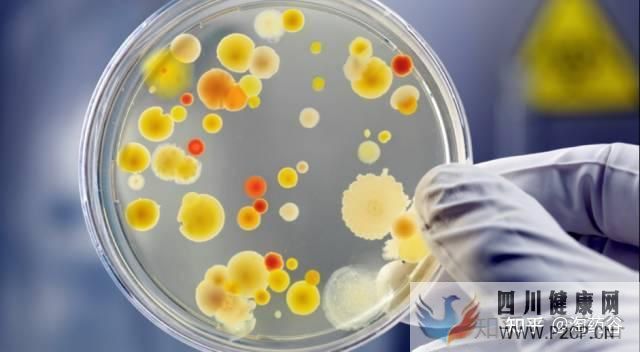
干细胞究竟有何作用呢(图6)

干细胞究竟有何作用呢
干(四声)细胞即为起源细胞。简单来讲,它是一类具有多向分化潜能和自我复制能力的原始的未分化细胞,是形成哺乳类动物的各组织器官的原始细胞。干细胞在形态上具有共性,通常呈圆形或椭圆形,细胞体积小,核相对较大,细胞核多为常染色质,具有较高的端粒酶活性。干细胞可分为胚胎干细胞和成体干细胞。
胎干细胞(Embryonic stem cell)的发育等级较高,是全能干细胞(Totipotent stem cell)
最新的研究表明,组织特异性干细胞同样具有分化成其他细胞或组织的潜能,这为干细胞的应用开创了更广泛的空间。
干细胞具有自我更新复制的能力(Self-renewing),能够产生高度分化的功能细胞。


当前,干细胞和再生医学的研究已成为自然科学中最为引人注目的领域。中国在干细胞低温超低温气相、液相保存技术、定向温度保存技术及超低温干细胞保存抗损伤技术等处于世界领先水平。干细胞理论的日臻完善和技术的迅猛发展必将在疾病治疗和生物医药等领域产生划时代的成果,是对传统医疗手段和医疗观念的一场重大革命。
采用干细胞治疗有着多种优势:低毒性(或无毒性),即使不完全了解疾病发病的确切机理治疗也可达到较好的治疗效果,自身干细胞移植可避免产生免疫排斥反应,对传统治疗方法疗效较差的疾病多有惊人的效果。


干细胞美容
人体的衰老,皱纹的出现,究其根源实质上都是细胞的衰老和减少。而细胞的衰老和减少则是由干细胞老化引起的。干细胞是各种组织细胞更新换代的种子细胞,是人体细胞的生产厂。干细胞族群的老化严重减弱了其增殖和分化的能力,新生的细胞补充不足,衰老细胞不能及时被替代,全身各系统功能下降,让人一天天老去。而你的皮肤,也因为皮肤干细胞的衰老而无法及时更新,衰老的皮肤得不到修复,所以,你有了皱纹,失去了青春容颜。干细胞美容原理是通过输注特定的多种细胞(包括各种干细胞和免疫细胞),激活人体自身的“自愈功能”,对病变的细胞进行补充与调控,激活细胞功能,增加正常细胞的数量,提高细胞的活性,改善细胞的质量,防止和延缓细胞的病变,恢复细胞的正常生理功能,从而达到疾病康复、对抗衰老的目的。

2011年5月,《自然》期刊发表研究报告指出,用皮肤干细胞制成的细胞组织,尽管是来自同一病患体内的细胞,都可能受到病患体内免疫系统的排斥,这项报告让干细胞治病的前景受到挫折。
研究人员是用与胚胎干细胞类似特点的皮肤细胞,制成诱发性多能干细胞(induced pluripotent stem cells,简称iPS细胞)。这种细胞理论上可变为神经、心脏、肝脏或其他器官的细胞,也可进行移植,修补受损的器官。
iPS细胞2007年最初制成时,科学家深感震撼,因为这种细胞具有胚胎细胞缺乏ips细胞在人类研究疾病工作中的用途的两大优点,一是没有争议,无需毁坏人类胚胎;二是因用病患本身的皮肤细胞制成,所以应当不会受到免疫系统的排斥。


分化后的细胞,往往由于高度分化而完全丧失了再分化的能力,这样的细胞最终将衰老和死亡。然而,诱导性多功能干细胞(iPS)的基本实验思路动物体在发育的过程中,体内却始终保留了一部分未分化的细胞,这就是干细胞,干细胞的衰老是机体衰老或人类衰老的重要因素,因而,人体干细胞移植(或注射)对阻止人类衰老意义重大。干细胞又叫做起源细胞、万用细胞,是一类具有自我更新和分化潜能的细胞。可以这样说,动物体就是通过干细胞的分裂来实现细胞的更新,从而保证动物体持续生长发育的。
干细胞根据其分化潜能的大小,可以分为两类:全能干细胞和组织干细胞。前者可以分化、发育成完整的动物个体,后者则是一种或多种组织器官的起源细胞。人的胚胎干细胞可以发育成完整的人,所以属于全能干细胞。


自体干细胞免疫治疗哮喘、气管炎、肺气肿、肺心病等
干细胞免疫疗法是通过调控细胞因子,修复受损的组织细胞,然后通过细胞间的相互作用及产生细胞因子抑制受损细胞的增殖及其免疫反应,从而发挥免疫重建的功能。从根本上消除哮喘病的发病基础。这些治疗方法在观念上完全不同于传统的治疗方法,主要强调通过修复人体免疫细胞来治疗哮喘病等呼吸道疾病。自体干细胞经北京京华友好医院现代医学临床证实,干细胞免疫疗法对哮喘出现的咳嗽、多痰、胸闷等症状有明显的治疗作用。具有疗效快、疗程短、不易复发等优点,突破了以往“治疗见效——停药复发”的弊端。其针对哮喘病特性经过细胞培养实验室特殊培养的愈喘干细胞,可以增强患者自身免疫力,舒张平滑肌,促进体内新陈代谢,修复呼吸系统损伤,激活肺部细胞再生,全面调理脾肺肾,激活肺部细胞再生修复肺通气功能,增强肺功能,充足提供肺部供氧,彻底修复肺、气道粘膜,恢复纤毛的排污能力。经过目前百余例的临床案例见证,其治愈率可到98%。后期配合中药调理,可长效地控制病情,是目前治疗哮喘病、气管炎最理想、最规范的治疗方法。


干细胞治疗肾病
1.干细胞移植治疗肾病的原理:
因干细胞具有“无限”增殖,多向分化潜能,具有造血支持,免疫调控和自我复制等特点。可作为理想的“种子”细胞用于病变引起的组织器官损伤修复。近年来基础研究发现干细胞可分化成肾固有细胞,肾实质细胞等,所以干细胞移植后对肾脏功能具有良好的修复和重建作用。
干细胞移植治疗自闭症
脐血干细胞和脐带间充质干细胞具有免疫调节和改善脑内微循环的功能。干细胞进入体内可调节机体免疫功能,并通过自身分化和分泌细胞因子和神经肽刺激新生血管形成,改善脑内缺血缺氧状态,激活和修复脑内受损的神经细胞。通过联合移植脐血单个核细胞和脐带间充质干细胞有助于改善患儿的语言交流能力、社会交往能力等。
生物修复疗法治疗范围
自身免疫性肝病是由自身免疫反应引起的一种特殊类型的慢性肝病,过去认为自身免疫性肝病比较罕见,近年来由于对此类疾病认识不断深入以及有关免疫学检查方法和相关检查方法的引进和提高,临床上发现中国人群中自身免疫性肝病的患者不断增多。临床常见的自身免疫性肝病包括自身免疫性肝炎、原发性胆汁性肝硬化及原发性硬化性胆管炎,很多自身免疫性肝病患者还伴有其他自身免疫性疾病如干燥综合症、类风湿性关节炎等等。

治疗糖尿病根据干细胞来源可分为胚胎干细胞和成体干细胞,在适合的环境下干细胞可以向各种细胞分化,如同“种子”一样在各种组织器官中生长,将一定数量的自体干细胞,经诱导、纯化、处理,回输患者体内,分化、增殖为胰岛样细胞,替代损伤的胰岛B细胞分泌胰岛素,起到治疗糖尿病的作用。
糖尿病主要分为1型糖尿病和2型糖尿病,糖尿病是一种特异性针对胰岛B细胞的自身免疫性疾病,其发病机制复杂,患者一旦诊断成立需终身依赖胰岛素,但是因为患者缺乏生理的血糖感应系统,这种替代治疗缺乏反馈调节,不符合生理需求,可导致全身性代谢紊乱而并发身体重要器官损害。虽然可通过胰腺移植和胰岛移植能达到不依赖胰岛素的效果,但供体困难和抗排异限制了临床应用,而干细胞作为一类具有自我更新和多向分化潜能的细胞,已逐渐成为人们寻找替代患者自身免疫系统破坏的胰岛细胞的新资源。





